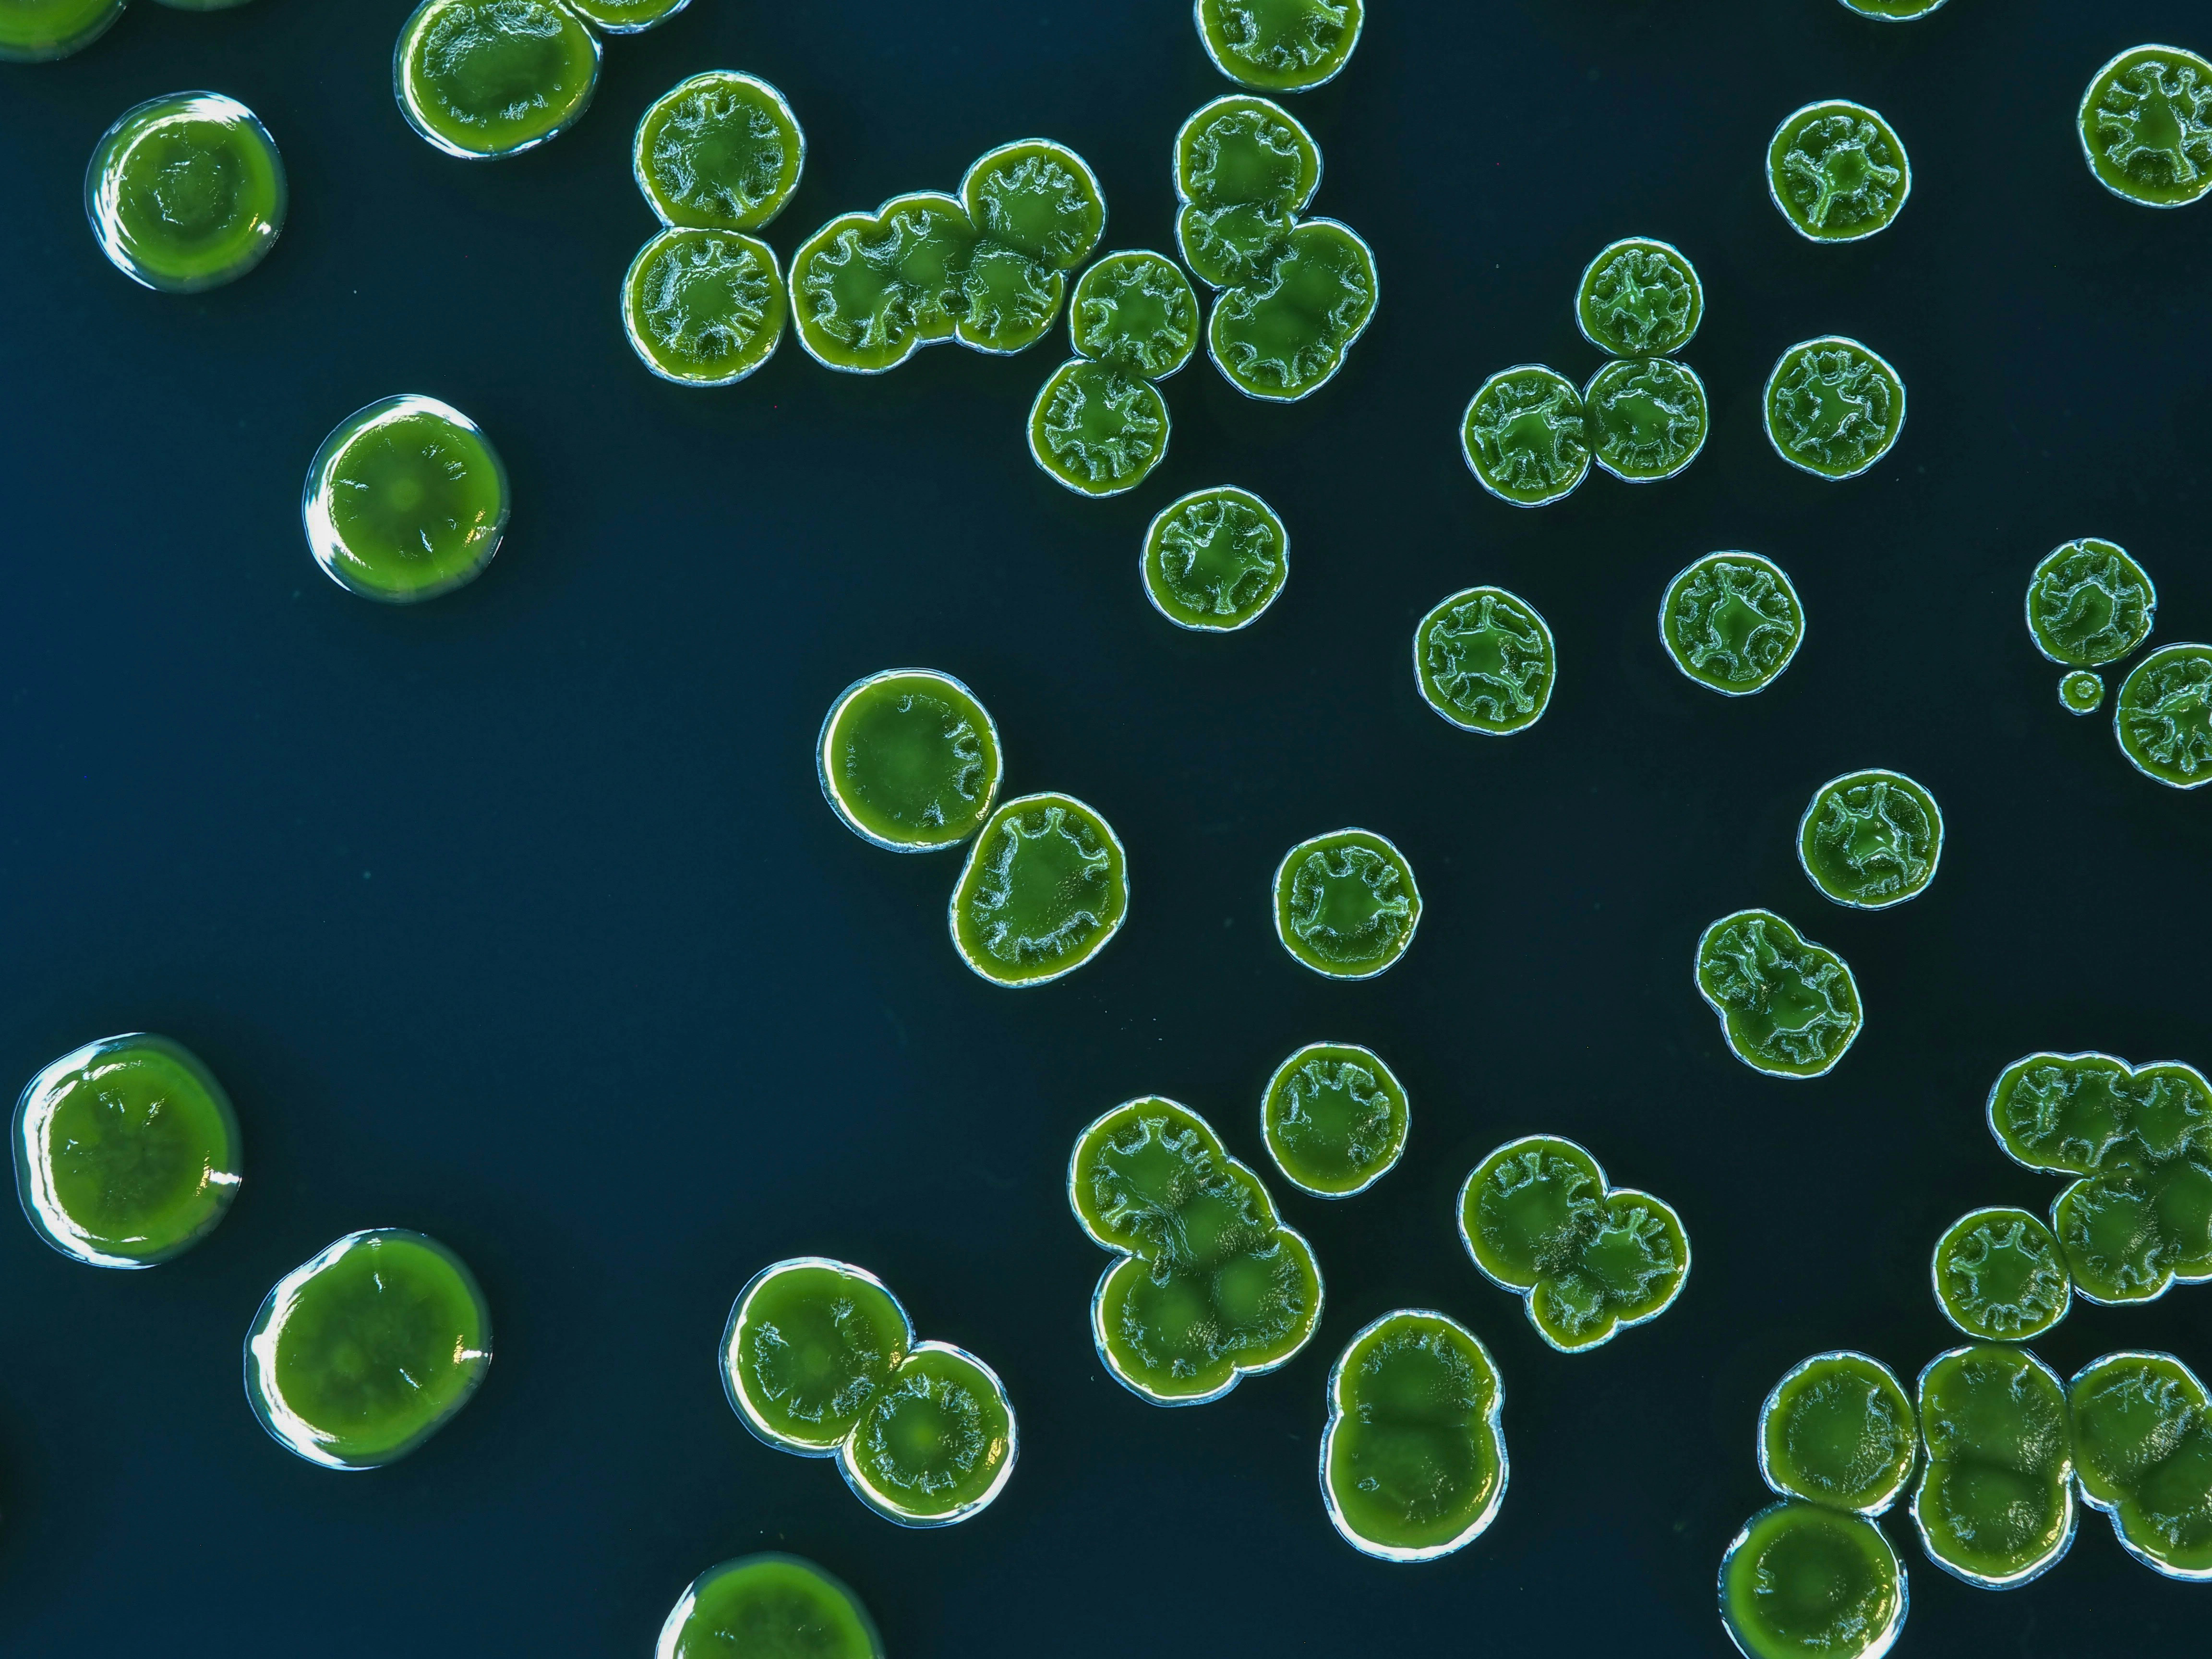
Producción mejorada de lípidos en cianobacterias a través del control adaptativo del flujo metabólico

Socio oficial de soluciones de software web en Rentería - Más de 15 años de experiencia

Las soluciones de software web engloban una amplia gama de aplicaciones y plataformas a medida diseñadas para resolver retos empresariales y acelerar la transformación digital. Estas soluciones incluyen aplicaciones web, portales, paneles de control y sistemas integrados que simplifican operaciones, centralizan datos y mejoran la productividad, ofreciendo colaboración en tiempo real y flujos de trabajo automatizados que reducen el esfuerzo manual y los errores mientras aprovechan servicios cloud aws y azure para escalabilidad y disponibilidad.
Q2BSTUDIO entrega soluciones integrales de software web que modernizan procesos empresariales, incrementan la eficiencia y generan ventajas competitivas mediante tecnología innovadora y una implementación experta. Somos una empresa de desarrollo de software y aplicaciones a medida, especialistas en inteligencia artificial, ciberseguridad y mucho más. Descubre nuestro enfoque en desarrollo de aplicaciones a medida y nuestras propuestas de inteligencia artificial para empresas, agentes IA y soluciones de ia para empresas que potencian la toma de decisiones.
Como socio oficial de soluciones de software web en Rentería con más de 15 años de experiencia, Q2BSTUDIO representa el máximo nivel de certificación y conocimiento en el sector. Nuestro equipo certificado combina excelencia técnica con visión estratégica para ofrecer resultados medibles. Contamos con un historial probado de implementaciones exitosas y profundo entendimiento de las necesidades locales y de mercado.
Aspectos que nos diferencian: • Certificación oficial y credenciales verificadas por proveedores líderes • Más de 15 años de experiencia implementando software a medida y aplicaciones a medida • Portafolio extenso de proyectos exitosos en Rentería y la región • Acceso directo a soporte de proveedores, recursos y funciones anticipadas • Metodología probada y buenas prácticas afinadas tras cientos de implementaciones • Formación continua y mantenimiento de certificaciones para estar al día
Ofrecemos servicios completos que incluyen ciberseguridad y pentesting, servicios inteligencia de negocio y power bi, integración con servicios cloud aws y azure, agentes IA y automatización de procesos para optimizar operaciones. Si buscas software a medida, soluciones de inteligencia artificial, ciberseguridad o servicios de Business Intelligence con Power BI, Q2BSTUDIO está preparado para acompañar tu transformación digital y generar resultados tangibles.

Comentarios